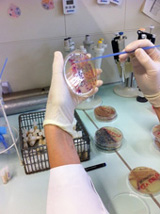

Is the eradication of multi-drug resistant bacteria (MRSA and ESBL-E) on pig farms feasible?
Colonisation of livestock with multi-drug resistant bacteria that respond to a limited number of antibiotics is considered as a possible risk factor for the introduction of multi-drug resistant pathogens into the food chain. On a model pig farm, German scientists for the first time demonstrated that extensive disinfection of the stable can be successfully used as a means of eradicating both antibiotic resistant ESBL-E and LA-MRSA from the stable environment. Applied and Environmental Microbiology reports on this in its online edition of 4 September 2015.
 Sub-culturing individual ESBL-E colonies for further analysis in the lab
Source: University of Bonn, Ricarda Schmithausen
Sub-culturing individual ESBL-E colonies for further analysis in the lab
Source: University of Bonn, Ricarda Schmithausen
The use of antibiotics in animal farming and the spread of multi-drug resistant pathogens along the food production chain is considered as a risk factor for the increasing detection of livestock-associated multi-drug resistant bacterial strains to humans. Human pathogenic antibiotic-resistant bacterial strains have been identified in livestock, in particular on pig farms. In this context, methicillin resistant Staphylococcus aureus known as MRSA and extended spectrum beta lactamase forming enterobacteria (ESBL-E) are the most commonly encountered drug resistant pathogens in German pigs. Transmission of the antibiotic resistant bacteria represents an occupational risk factor for people working in the farm environment and, potentially, a risk factor for those consuming meat products.
To combat the increasing spread of multi-drug resistant pathogens in the food producing business, it is important to contain the spread and prevent stable-to-table transmission of resistant bacteria. However, pathogens can not only be found on or in the animals but are also present on contact surfaces, in the dust and water throughout the entire stable. Besides, personnel working in the farm business or living in the surroundings of the farm often become transient carriers of these strains. This additional source for introduction of multi-drug resistant bacteria into the stock represents a special challenge for elimination measures.
As part of a scientific collaboration, researchers of various institutes have now evaluated whether it would be possible to eradicate MRSA and ESBL-E pathogens in a pig farm through extensive cleaning and disinfection measures in stable buildings and stable installations. Scientists taking part in this collaboration included PD (associate professor) Dr. Isabelle Bekeredjian-Ding, head of Division EU Co-operation/ Microbiology at the Paul-Ehrlich-Institut, Professor Dr. Brigitte Petersen, head of the Department for Preventive Health Management at the Institute for Veterinary Science of the University of Bonn, Professor Dr. Gabriele Bierbaum, Institute for Medical Microbiology and Immunology, and Professor Dr. Martin Exner, Director of the Institute for Hygiene and Public Health, both belonging to the University Hospital of Bonn.
On the model farm where these measures were performed, LA-MRSA and ESBL-E had previously been identified in a routine hygiene monitoring action. In this context the farmer decided to fight the spread of MRSA and ESBL-E by extending his production range from piglet raising to raising of young sows, thus, reducing the requirement to purchase additional animals, and in doing so, the risk of introducing new pathogenic agents. To eliminate the pre-existing antibiotic resistant bacterial strains, the animals from the existing stock were culled, the entire facility decontaminated by a certified disinfection specialist (i.e. cleaned and disinfected), and an additional stable building added to the farm.
With the aid of swabs from the pigs, from air, water and dust, and from persons working or living on the farm, the scientists were able to prove that the LA-MRSA and ESBL-E present before decontamination were entirely eliminated.
No ESBL-E pathogens were detected within twelve months after the decontamination measure, which provides proof that the measure taken was effective. The originally circulating LA-MRSA strain was also eradicated. However, only two days after resumption of the farm business, a new LA-MRSA strain was detected in pigs and environmental samples. Its origin could not be clarified but with a delay of two months this strain was also recovered from farm staff.
One year after decontamination, the farmer reported positive effects including a better health status of the pigs with fewer intestinal infections and reduced use of antibiotics on the farm as a consequence.
"This example shows that it is possible to eradicate antibiotic-resistant bacterial strains from the farm environment. The major challenge is to develop new concepts for preventing re-introduction and spread of these pathogens"
, Dr. Bekeredjian-Ding explains the events.
Bekeredjian-Ding, previously a member of staff of the Institute for Medical Microbiology, Immunology and Parasitology at the University Hospital of Bonn has served as head of the Division of EU Co-Operation/Microbiology at the Paul-Ehrlich-Institut since January 2015. Together with the Division of Veterinary Medicine of the Paul-Ehrlich-Institut, headed by Dr. Veronika von Messling, and their colleagues at the Robert-Koch-Institute (RKI) and Friedrich-Löffler-Institut (FLI), these researchers are committed to studying and combating zoonoses (diseases transmittable from animals to humans) within the framework of the National Research Platform for Zoonoses.
Original Publication
Schmithausen RM, Kellner SR, Schulze-Geisthoevel SV, Hack S, Engelhart S, Bodenstein I, Al-Sabti N, Reif M, Fimmers R, Körber-Irrgang B, Harlizius J, Hoerauf A, Exner M, Bierbaum G, Petersen B, Bekeredjian-Ding I (2015): Eradication of methicillin-resistant Staphylococcus aureus and Enterobacteriaceae expressing extended-spectrum beta-lactamases on a model pig farm.
Appl Environ Microbiol 81: 7633-7643.
Online-Abstract
Press Contact:
Paul-Ehrlich-Institut
Press Office
Dr. Susanne Stöcker, Dr. Corinna Volz-Zang, Brigitte Morgenroth
Paul-Ehrlich-Straße 51-59
63225 Langen
GERMANY
Telefon: +49 6103 77 1030
Telefax: +49 6103 77 1262
Email: presse@pei.de
The Paul-Ehrlich-Institut, the Federal Institute for Vaccines and Biomedicines, in Langen near Frankfurt/Main is a senior federal authority reporting to the Federal Ministry of Health (Bundesministerium für Gesundheit, BMG). It is responsible for the research, assessment, and marketing authorisation of biomedicines for human use and immunological veterinary medicinal products. Its remit also includes the authorisation of clinical trials and pharmacovigilance, i.e. recording and evaluation of potential adverse effects.
Other duties of the institute include official batch control, scientific advice and inspections. In-house experimental research in the field of biomedicines and life science form an indispensable basis for the manifold tasks performed at the institute.
The Paul-Ehrlich-Institut, with its roughly 800 members of staff, also has advisory functions nationally (federal government, federal states (Länder)), and internationally (World Health Organisation, European Medicines Agency, European Commission, Council of Europe etc.).
top